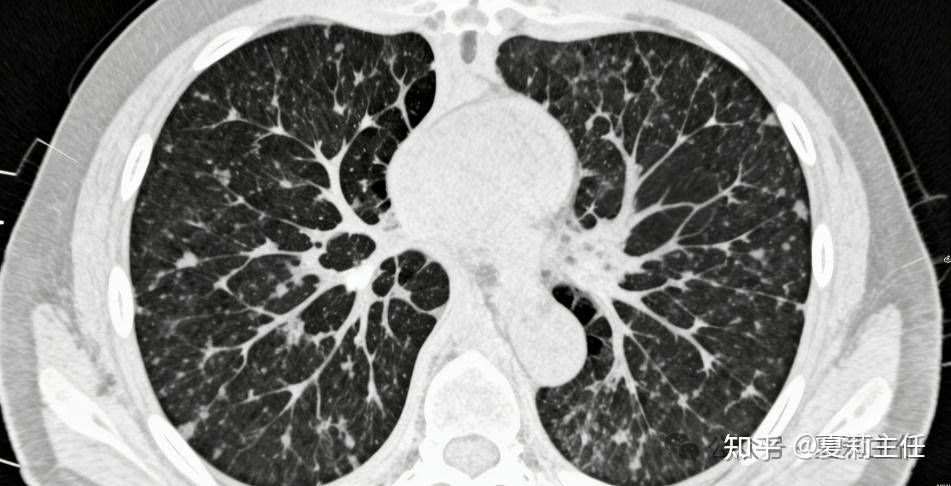

在肿瘤科诊室里,我见过太多患者听到 “浸润性肺癌” 这几个字时,眼神瞬间黯淡下来。大家都清楚,原位癌、微浸润癌相对安全,手术切除后基本能治愈;可一听到 “浸润性”,就难免直接和 “恶性程度高、预后不好” 挂钩,甚至一下子陷入绝望。
作为肿瘤科医生,我完全理解这份焦虑,但浸润性肺癌并非都是坏消息 —— 只要满足两个关键特征,5年生存率可接近100%,希望这份科普,能给迷茫中的你带去安心与力量。
这两个能带来 “好预后” 的特征其实并不复杂,我用大白话给大家讲明白:第一个是肿瘤以 “贴壁为主” 生长;第二个是 “高浸润成分占比不足20%”。
先说说什么是 “高浸润成分”?
简单讲,就是那些攻击性强的肺腺癌类型,比如微乳头型、实体型、复杂腺体型等。这类成分占比越少,肿瘤的 “恶性脾气” 就越温和,对身体的威胁也越小。
这两个特征结合在一起,本质上就是医学上的 “高分化浸润性肺癌”。我常跟患者打比方:高分化肿瘤就像肿瘤里的 “温和派”—— 它的细胞形态和正常肺细胞长得很像,没那么 “怪异”,也就意味着侵袭性、转移性都很弱,生长速度也相对缓慢。反观低分化肿瘤,细胞形态怪异,极具 “攻击性”,预后自然差一些。
大家担心浸润性肺癌,主要是怕它转移、难控制。但这类高分化的浸润性肺癌,因为恶性程度低,手术切除的效果非常好。而中分化、低分化的患者,有可能合并淋巴结转移,所以5年生存率数据没那么稳定,会有一定波动。
结合夏主任多年的诊疗经验:只要符合 “贴壁为主” 和 “高浸润成分不足20%” 这两个条件,通过规范的手术治疗,很多患者都能顺利回归正常生活,5年生存率更是接近100%,几乎和治愈没区别。
当然,并非所有浸润性肺癌都是 “温和派”。有些患者的肿瘤是低分化类型,恶性程度高、侵袭性强,甚至发现时已经到了中晚期。但即便如此,也千万别放弃!随着医学进步,这类肺癌的治疗已经进入 “精准控制” 时代,有多种手段可以应对:
比如精准放疗,就像 “导航导弹”,能精准锁定肿瘤、避开正常组织,用高剂量杀灭癌细胞,还能减少副作用:
- 局部晚期患者,靠它能缩小肿瘤,争取手术机会;
- 晚期转移患者,可针对性消灭转移灶,配合全身治疗实现长期带瘤生存;
- 不耐受手术、化疗的患者,也能靠它控制病情、提升生活质量。
除了精准放疗,还有其他精准治疗手段:
- 有基因突变的患者,靶向治疗副作用小,能把生存期延长3-5年甚至更久;
- 没有基因突变的患者,免疫治疗联合精准化疗,也能显著提升疗效、延长生存期。
肿瘤科夏莉主任在此强调
拿到“浸润性肺癌”报告先别急!早期有极大治愈可能,中晚期也有成熟控制手段,关键是和医生充分沟通。病情的可怕不在分期,而在被“癌症”二字吓倒。每一种肿瘤都有它的“性格”,每一位患者的情况也都是独特的。只要相信科学、积极配合治疗,就一定能等到转机,守住希望!
从事肿瘤内科临床40余年,专攻肺癌、肝癌、乳腺癌、胃癌、胰腺癌等恶性肿瘤的精准诊断与个体化治疗,不少经夏主任规范治疗的癌症患者,不适症状得到缓解,生存质量明显提升。
患者家属可提交相关检查报告,夏主任会结合丰富临床经验为您分析病情、明确治疗方向,用专业且易懂的建议,缓解大家的就医顾虑。